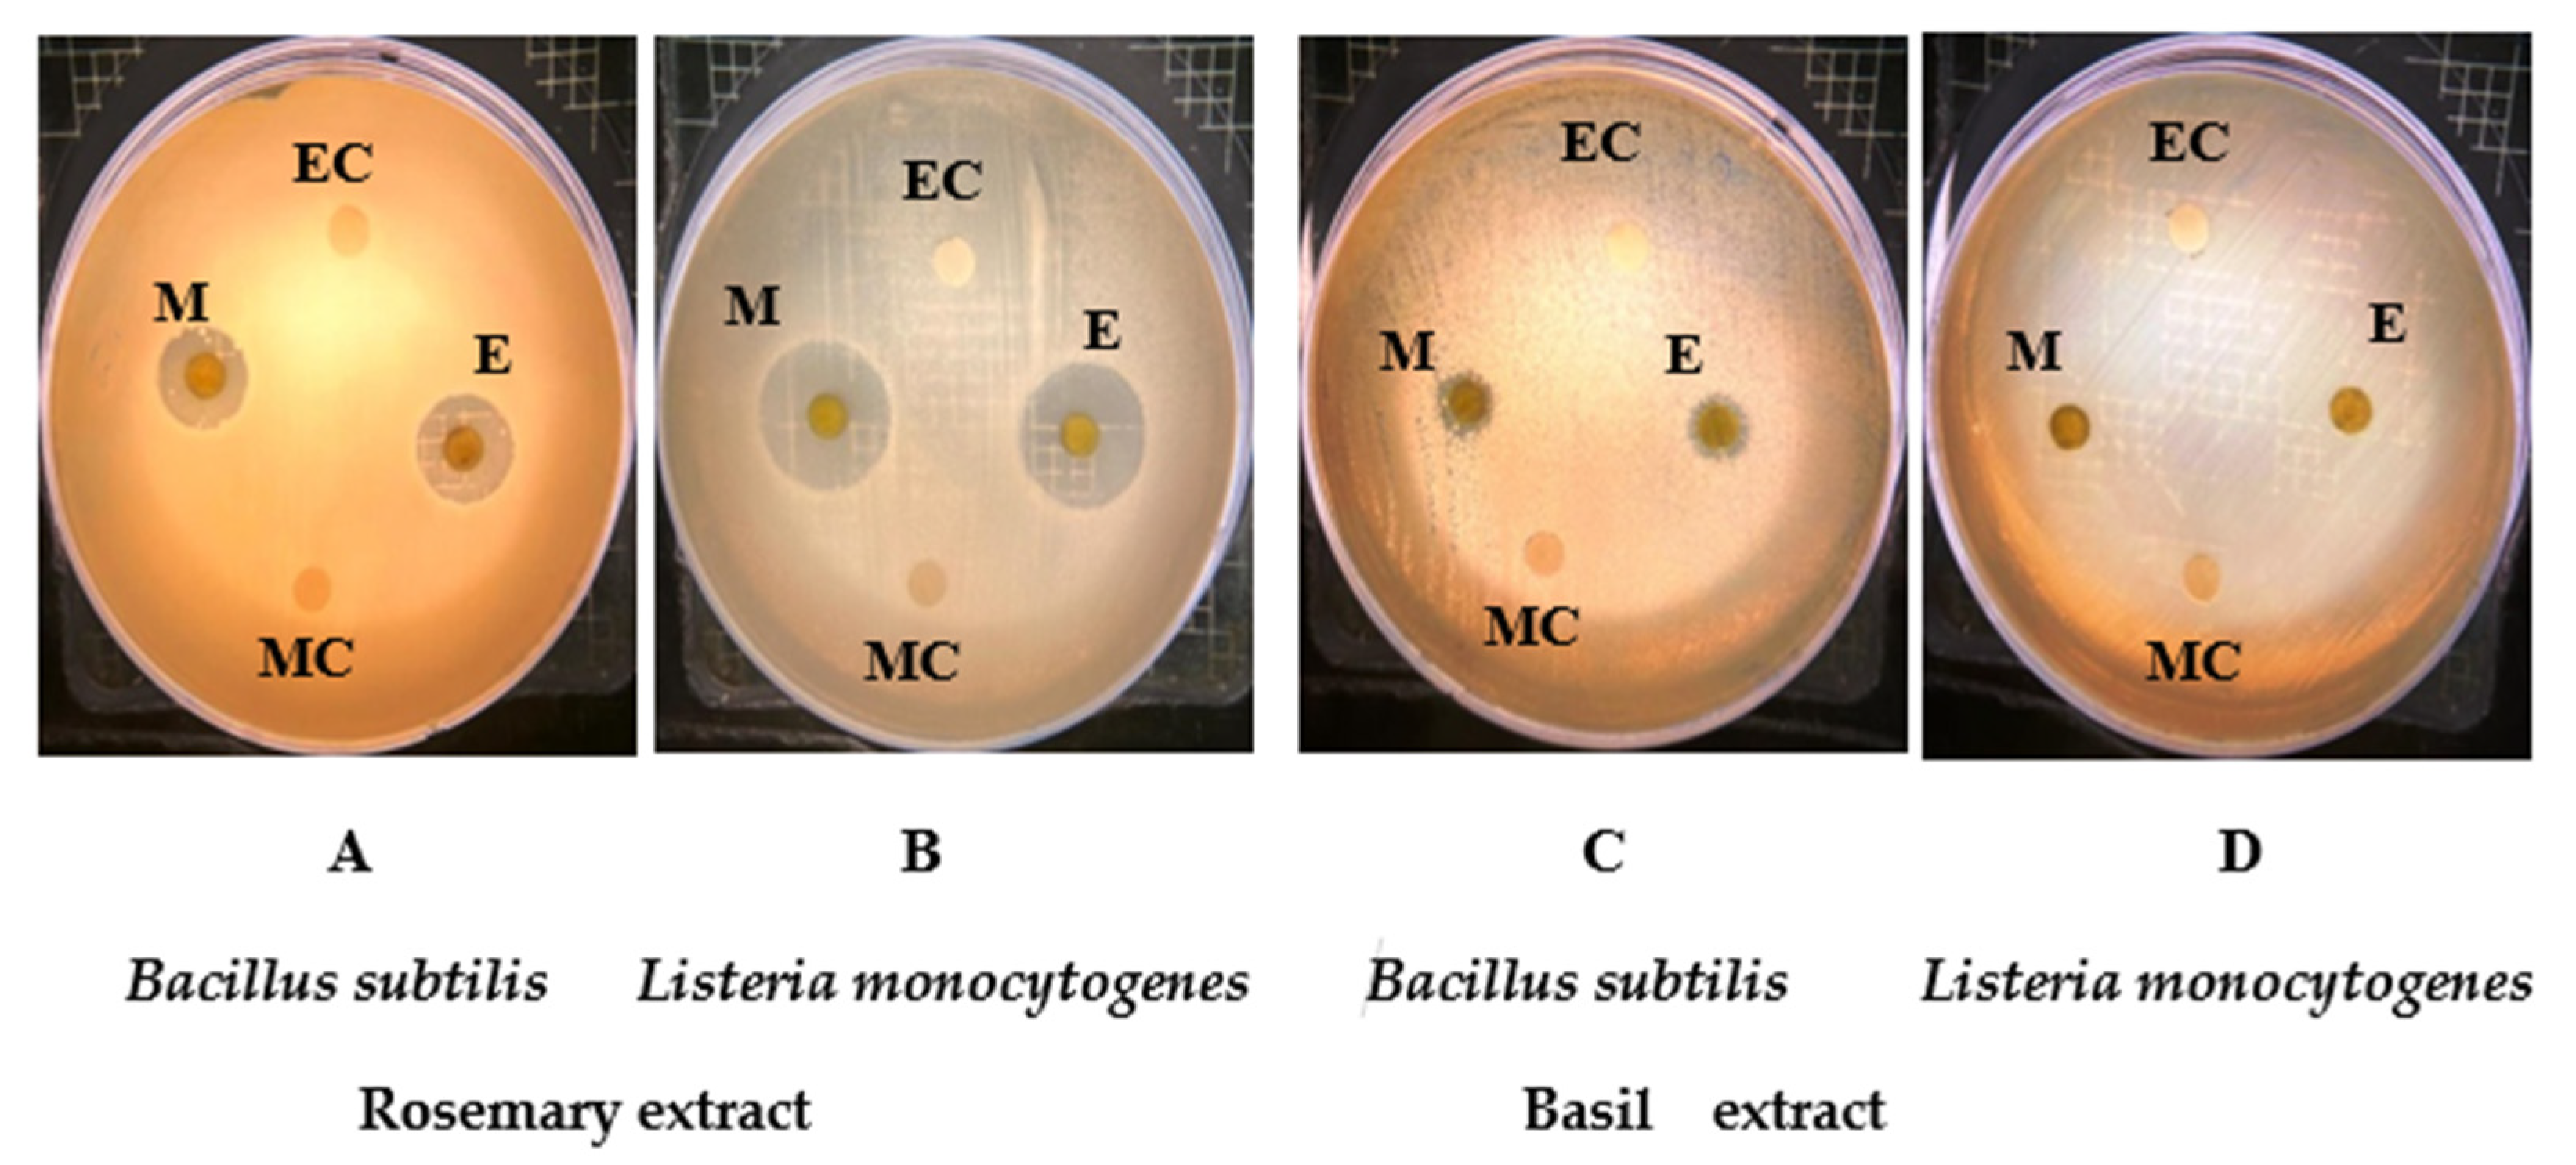

Boiling Technique-Based Food Processing Effects on the Bioactive and Antimicrobial Properties of Basil and Rosemary
Abstract
:1. Introduction
2. Results and Discussion
2.1. Effect of Boiling on Total Polyphenol Content of Basil and Rosemary
2.2. Effect of Boiling on Total Flavonoid Content of Basil and Rosemary
2.3. Effect of Boiling on DPPH Scavenging of Basil and Rosemary
2.4. Effect of Boiling on Ferric Reducing Power of Basil and Rosemary
2.5. Antimicrobial Activity
2.6. HPLC Analysis of Phenolic Compounds
3. Materials and Methods
3.1. Raw Materials
3.2. Preparation of Phenolic Extracts
3.3. Total Polyphenol Content (TPC)
3.4. Total Flavonoid Content (TFC)
3.5. DPPH Scavenging
3.6. Reducing Power
3.7. Bacterial Strains
3.8. Antibiotic Proprieties of Basil and Rosemary
3.9. Determination of Minimum Inhibitory and Minimum Bactericidal Concentrations
3.10. HPLC Analysis of Phenolic Compounds
3.11. Statistical Analysis
4. Conclusions
Author Contributions
Funding
Institutional Review Board Statement
Informed Consent Statement
Data Availability Statement
Conflicts of Interest
Sample Availability
References
- Liu, Z.; Ren, Z.; Zhang, J.; Chuang, C.C.; Kandaswamy, E.; Zhou, T.; Zuo, L. Role of ROS and nutritional antioxidants in human diseases. Front. Physiol. 2018, 9, 477. [Google Scholar] [CrossRef] [Green Version]
- Auten, R.L.; Davis, J.M. Oxygen toxicity and reactive oxygen species: The devil is in the details. Pediatric Res. 2009, 66, 121–127. [Google Scholar] [CrossRef] [Green Version]
- Langseth, L. Oxidants, Antioxidants, and Disease Prevention; ILSI Europe: Brussels’s, Belgium, 1995. [Google Scholar]
- Gutteridge, J.M.; Halliwell, B. Free radicals and antioxidants in the year 2000. A historical look to the future. Ann. N Y. Acad. Sci. 2000, 899, 136–147. [Google Scholar] [CrossRef]
- McCord, J.M. The evolution of free radicals and oxidative stress. Am. J. Med. 2000, 108, 652–659. [Google Scholar] [CrossRef]
- Gilgun-Sherki, Y.; Melamed, E.; Offen, D. Oxidative stress induced-neurodegenerative diseases: The need for antioxidants that penetrate the blood brain barrier. Neuropharmacology 2001, 40, 959–975. [Google Scholar] [CrossRef]
- Embuscado, M.E. Herbs and spices as antioxidants for food preservation. In Handbook of Antioxidants for Food Preservation; Elsevier Inc: Amsterdam, The Netherlands, 2015; pp. 251–283. [Google Scholar]
- Kaefer, C.M.; Milner, J.A. The role of herbs and spices in cancer prevention. J. Nutr. Biochem. 2008, 19, 347–361. [Google Scholar] [CrossRef] [Green Version]
- Kheroda Devi, M.; Thangjam, I.; Singh, W. Phytochemical screening of selected twelve medicinal plants commonly used as spices and condiments in manipur, north-east India. Int. J. Curr. Res. Life Sci. 2019, 8, 2945–2947. [Google Scholar]
- Firenzuoli, F.; Gori, L. Herbal medicine today: Clinical and research issues. Evid. Based Complement. Altern. Med. 2007, 4, 37–40. [Google Scholar] [CrossRef]
- Park, J.B. Identification and quantification of a major anti-oxidant and anti-inflammatory phenolic compound found in basil, lemon thyme, mint, oregano, rosemary, sage, and thyme. Int. J. Food Sci. Nutr. 2011, 62, 577–584. [Google Scholar] [CrossRef] [PubMed]
- Simon, J.E.; Morales, M.R.; Phippen, W.B.; Vieira, R.F.; Hao, Z. Basil: A source of aroma compounds and a popular culinary and ornamental herb. Perspect. New Crop. New Uses 1999, 16, 499–505. [Google Scholar]
- Mohan, L.; Amberkar, M.; Kumari, M. Ocimum sanctum linn. (TULSI)-an overview. Int. J. Pharm. Sci. Rev. Res. 2011, 7, 51–53. [Google Scholar]
- Rahman, S.; Islam, R.; Kamruzzaman, M.; Alam, K.; Jamal, A. Ocimum sanctum L.: A review of phytochemical and pharmacological profile. Am. J. Drug Discov. Develop. 2011, 1, 1–15. [Google Scholar]
- Pattanayak, P.; Behera, P.; Das, D.; Panda, S.K. Ocimum sanctum Linn. A reservoir plant for therapeutic applications: An overview. Pharmacogn. Rev. 2010, 4, 95–105. [Google Scholar] [CrossRef] [PubMed] [Green Version]
- Mondal, S.; Mirdha, B.R.; Mahapatra, S.C. The science behind sacredness of Tulsi (Ocimum sanctum Linn.). Indian. J. Physiol. Pharmacol. 2009, 53, 291–306. [Google Scholar]
- Narendhirakannan, R.; Subramanian, S.; Kandaswamy, M. Biochemical evaluation of antidiabetogenic properties of some commonly used Indian plants on streptozotocin-induced diabetes in experimental rats. Clin. Exp. Pharmacol. Physiol. 2006, 33, 1150–1157. [Google Scholar] [CrossRef]
- Goel, R.K.; Sairam, K.; Dorababu, M.; Prabha, T.; Rao Ch, V. Effect of standardized extract of Ocimum sanctum Linn. on gastric mucosal offensive and defensive factors. Indian J. Exp. Biol. 2005, 43, 715–721. [Google Scholar]
- Kelm, M.A.; Nair, M.G.; Strasburg, G.M.; DeWitt, D.L. Antioxidant and cyclooxygenase inhibitory phenolic compounds from Ocimum sanctum Linn. Phytomedicine 2000, 7, 7–13. [Google Scholar] [CrossRef]
- Prakash, J.; Gupta, S.K. Chemopreventive activity of Ocimum sanctum seed oil. J. Ethnopharmacol. 2000, 72, 29–34. [Google Scholar] [CrossRef]
- Vasudevan, P.; Kashyap, S.; Sharma, S. Bioactive Botanicals from Basil (Ocimum sp.). J. Sci. Res. 1999, 58, 332–338. [Google Scholar]
- Cohen, M.M. Tulsi-Ocimum sanctum: A herb for all reasons. J. Ayurved. Integrat. Med. 2014, 5, 251. [Google Scholar] [CrossRef] [Green Version]
- Anbarasu, K.; Vijayalakshmi, G. Improved shelf life of protein-rich tofu using Ocimum sanctum (tulsi) extracts to benefit Indian rural population. J. Food Sci. 2007, 72, M300–M305. [Google Scholar] [CrossRef] [PubMed]
- Shishodia, S.; Majumdar, S.; Banerjee, S.; Aggarwal, B.B. Ursolic acid inhibits nuclear factor-kappaB activation induced by carcinogenic agents through suppression of IkappaBalpha kinase and p65 phosphorylation: Correlation with down-regulation of cyclooxygenase 2, matrix metalloproteinase 9, and cyclin D1. Cancer Res. 2003, 63, 4375–4383. [Google Scholar]
- Scagel, C.F.; Lee, J. Phenolic composition of basil plants is differentially altered by plant nutrient status and inoculation with mycorrhizal fungi. HortScience 2012, 47, 660–671. [Google Scholar] [CrossRef]
- Nurzynska-Wierdak, R. Sweet basil (Ocimum basilicum L.) flowering affected by foliar nitrogen application. Acta Agrobotan. 2011, 64, 57–64. [Google Scholar] [CrossRef] [Green Version]
- Kruma, Z.; Andjelkovic, M.; Verhe, R.; Kreicbergs, V.; Karklina, D.; Venskutonis, P. Phenolic compounds in basil, oregano and thyme. Foodbalt 2008, 5, 99–103. [Google Scholar]
- Hussain, A.I.; Anwar, F.; Hussain Sherazi, S.T.; Przybylski, R. Chemical composition, antioxidant and antimicrobial activities of basil (Ocimum basilicum) essential oils depends on seasonal variations. Food Chem. 2008, 108, 986–995. [Google Scholar] [CrossRef]
- Duke, J.A. Handbook of Medicinal Herbs; CRC Press: Boca Raton, NY, USA, 2000; pp. 630–632. [Google Scholar]
- Ghasemzadeh, R.M.; Hosseinzadeh, H. Therapeutic effects of rosemary (Rosmarinus officinalis L.) and its active constituents on nervous system disorders. Iran J. Basic Med. Sci. 2020, 23, 1100–1112. [Google Scholar]
- United States Department of Agriculture, Agricultural Research Services USDA. National Nutrient Database for Standard Reference, Release 25. NutrientData Laboratory. 2015. Available online: http://ndb.nal.usda.gov/ndb/foods/show/256 (accessed on 30 November 2021).
- Touafek, O.; Nacer, A.; Kabouche, A.; Kabouche, Z.; Bruneau, C. Chemical composition of the essential oil of Rosmarinus officinalis cultivated in the Algerian Sahara. Chem. Nat. Comp. 2004, 40, 28–29. [Google Scholar] [CrossRef]
- Begum, A.; Sandhya, S.; Shaffath Ali, S.; Vinod, K.R.; Reddy, S.; Banji, D. An in-depth review on the medicinal flora Rosmarinus officinalis (Lamiaceae). Acta Sci. Pol. Technol. Aliment. 2013, 12, 61–73. [Google Scholar] [PubMed]
- Atti-Santos, A.C.; Rossato, M.; Pauletti, G.F.; Rota, L.D.; Rech, J.C.; Pansera, M.R.; Agostini, F.; Serafini, L.A.; Moyne, P. Physico-chemical evaluation of Rosmarinus officinalis L. essential oils. Braz. Arch. Biol. Technol. 2005, 48, 1035–1039. [Google Scholar] [CrossRef] [Green Version]
- Tawfeeq, A.A.; Mahdi, M.F.; Abaas, I.S.; Alwan, A.H. Phytochemical and antibacterial studies of leaves of Rosmarinus officinalis cultivated in Karbala, Iraq. Al-Mustansiriyah J. Pharmaceut. Sci. 2018, 17, 9. [Google Scholar]
- Jiang, Y.; Wu, N.; Fu, Y.J.; Wang, W.; Luo, M.; Zhao, C.J.; Zu, Y.G.; Liu, X.L. Chemical composition and antimicrobial activity of the essential oil of rosemary. Environ. Toxicol. Pharmacol. 2011, 32, 63–68. [Google Scholar] [CrossRef]
- Bendeddouche, M.S.; Benhassaini, H.; Hazem, Z.; Romane, A. Essential oil analysis and antibacterial activity of Rosmarinus tournefortii from Algeria. Nat. Prod. Commun. 2011, 6, 1511–1514. [Google Scholar] [CrossRef] [Green Version]
- Bai, N.; He, K.; Roller, M.; Lai, C.S.; Shao, X.; Pan, M.H.; Ho, C.T. Flavonoids and phenolic compounds from Rosmarinus officinalis. J. Agric. Food. Chem. 2010, 58, 5363–5367. [Google Scholar] [CrossRef] [PubMed]
- del Bano, M.J.; Lorente, J.; Castillo, J.; Benavente-Garcia, O.; Marin, M.P.; Del Rio, J.A.; Ortuno, A.; Ibarra, I. Flavonoid distribution during the development of leaves, flowers, stems, and roots of Rosmarinus officinalis: Postulation of a biosynthetic pathway. J. Agric. Food Chem. 2004, 52, 4987–4992. [Google Scholar] [CrossRef] [PubMed]
- Samuelsson, G.; Bohlin, L. Drugs of Natural Origin. A Treatise of Pharmacognosy; CRC Press Inc.: Boca Raton, FL, USA; London, UK, 2017. [Google Scholar]
- Chan, E.W.C.; Kong, L.Q.; Yee, K.Y.; Chua, W.Y.; Loo, T.Y. Antioxidant and antibacterial properties of some fresh and dried Labiatae herbs. Free Radic. Antiox. 2012, 2, 20–27. [Google Scholar] [CrossRef] [Green Version]
- Larrauri, J.A.; Ruperez, P.; Saura-Calixto, F. Effect of drying temperature on the stability of polyphenols and antioxidant activity of red grape pomace peels. J. Agric. Food Chem. 1997, 45, 1390–1393. [Google Scholar] [CrossRef]
- Dewanto, V.; Wu, X.Z.; Adom, K.K.; Liu, R.H. Thermal processing enhances the nutritional value of tomatoes by increasing total antioxidant activity. J. Agric. Food Chem. 2002, 50, 3010–3014. [Google Scholar] [CrossRef]
- Kim, S.Y.; Jeong, S.M.; Kim, S.J.; Jeon, K.I.; Park, E.; Park, H.R.; Lee, S.C. Effects of heat treatment on the antioxidative and antigenotoxic activity of extracts from persimmon (Diospyros kaki L.) peel. Biosci. Biotechnol. Biochem. 2006, 70, 999–1002. [Google Scholar] [CrossRef] [PubMed] [Green Version]
- Salamatullah, A.M.; Özcan, M.M.; Alkaltham, M.S.; Uslu, N.; Hayat, K. Influence of boiling on total phenol, antioxidant activity, and phenolic compounds of celery (Apium graveolens L) root. J. Food Proc. Preserv. 2021, 45, e15171. [Google Scholar] [CrossRef]
- Hayat, K.; Abbas, S.; Hussain, S.; Shahzad, S.A.; Tahir, M.U. Effect of microwave and conventional oven heating on phenolic constituents, fatty acids, minerals and antioxidant potential of fennel seed. Ind. Crop. Prod. 2019, 140, 111610. [Google Scholar] [CrossRef]
- Karrar, E.; Sheth, S.; Wei, W.; Wang, X.G. Effect of microwave heating on lipid composition, oxidative stability, color value, chemical properties, and antioxidant activity of gurum (Citrullus lanatus var. Colocynthoide) seed oil. Biocatal. Agric. Biotechnol. 2020, 23, 101504. [Google Scholar] [CrossRef]
- Elisabetta, D.; Patricia, C.; Gabriele, R.; Biancamaria, S.; Luca, T.; Elizabeth, J.; Dalene, D.B.; Luigi, L. Impact of cold versus hot brewing on the phenolic profile and antioxidant capacity of Rooibos (Aspalathus linearis) herbal tea. Antioxidants 2019, 8, 499. [Google Scholar]
- Gunathilake, K.; Ranaweera, K.; Rupasinghe, H.P.V. Effect of different cooking methods on polyphenols, carotenoids and antioxidant activities of selected edible leaves. Antioxidants 2018, 7, 117. [Google Scholar] [CrossRef] [Green Version]
- Salamatullah, A.M.; Uslu, N.; Özcan, M.M.; Alkaltham, M.S.; Hayat, K. The effect of oven drying on bioactive compounds, antioxidant activity, and phenolic compounds of white and red-skinned onion slices. J. Food Proc. Preserv. 2021, 45, e15173. [Google Scholar] [CrossRef]
- Vinha, A.F.; Alves, R.C.; Barreira, S.V.; Costa, A.S.; Oliveira, M.B. Impact of boiling on phytochemicals and antioxidant activity of green vegetables consumed in the Mediterranean diet. Food Funct. 2015, 6, 1157–1163. [Google Scholar] [CrossRef]
- Arias-Rico, J.; Macias-Leon, F.J.; Alanis-Garcia, E.; Cruz-Cansino, N.D.S.; Jaramillo-Morales, O.A.; Barrera-Galvez, R.; Ramirez-Moreno, E. Study of edible plants: Effects of boiling on nutritional, antioxidant, and physicochemical properties. Foods 2020, 9, 599. [Google Scholar] [CrossRef]
- Nie, Y.; Yu, M.; Zhou, H.; Zhang, P.; Yang, W.; Li, B. Effect of boiling time on nutritional characteristics and antioxidant activities of Lentinus edodes and its broth. CyTA J. Food 2020, 18, 543–550. [Google Scholar] [CrossRef]
- Mohammed, J.; Hateem, S.M.; Sattar, O.D.A. Effect of aqueous, alcoholic and acidic extract of rosemary leaves Rosmarinus officinalis in inhibiting the effect of free radicals manufactured and inhibitory effect in some microorganisms and detection of some active compounds. J. Phys. Conf. Ser. 2020, 1664, 012079. [Google Scholar] [CrossRef]
- Pankey, G.A.; Sabath, L.D. Clinical relevance of bacteriostatic versus bactericidal mechanisms of action in the treatment of Gram-positive bacterial infections. Clin. Infect. Dis. 2004, 38, 864–870. [Google Scholar] [CrossRef] [PubMed] [Green Version]
- Gonelimali, F.D.; Lin, J.; Miao, W.; Xuan, J.; Charles, F.; Chen, M.; Hatab, S.R. Antimicrobial properties and mechanism of action of some plant extracts against food pathogens and spoilage microorganisms. Front. Microbiol. 2018, 9, 1639. [Google Scholar] [CrossRef]
- Peng, Y.; Yuan, J.; Liu, F.; Ye, J. Determination of active components in rosemary by capillary electrophoresis with electrochemical detection. J. Pharm. Biomed. Anal. 2005, 39, 431–437. [Google Scholar] [CrossRef] [PubMed]
- Kh, M. Antibacterial Effect of Allium sativum and Rosmarinus officinalis essential oil on major mastitis pathogens in dairy cattle. J. Cell Tissue 2014, 5, 79–88. [Google Scholar]
- Food Standards Agency, Approved additives and E numbers. Available online: https://www.food.gov.uk/business-guidance/approved-additives-and-e-numbers (accessed on 15 November 2021).
- Habtemariam, S. The therapeutic potential of rosemary (Rosmarinus officinalis) diterpenes for Alzheimer’s disease. Evid. Based Complement. Alternat. Med. 2016, 2016, 2680409. [Google Scholar] [CrossRef] [Green Version]
- Andrade, J.M.; Faustino, C.; Garcia, C.; Ladeiras, D.; Reis, C.P.; Rijo, P. Rosmarinus officinalis L.: An update review of its phytochemistry and biological activity. Future Sci. OA 2018, 4, FSO283. [Google Scholar] [CrossRef] [Green Version]
- Elansary, H.O.; Szopa, A.; Kubica, P.; Ekiert, H.; El-Ansary, D.O.; Al-Mana, F.A.; Mahmoud, E.A. Saudi Rosmarinus officinalis and Ocimum basilicum L. polyphenols and biological activities. Processes 2020, 8, 446. [Google Scholar] [CrossRef] [Green Version]
- Flanigan, P.M.; Niemeyer, E.D. Effect of cultivar on phenolic levels, anthocyanin composition, and antioxidant properties in purple basil (Ocimum basilicum L.). Food Chem. 2014, 164, 518–526. [Google Scholar] [CrossRef] [PubMed]
- Hayat, K. Impact of drying methods on the functional properties of peppermint (Mentha piperita L.) leaves. Sci. Lett 2020, 8, 36–42. [Google Scholar]
- Gülçìn, İ.; Kìreçì, E.; Akkemìk, E.; Topal, F.; Hisar, O. Antioxidant and antimicrobial activities of an aquatic plant: Duckweed (Lemna minor L.). Turk. J. Biol. 2010, 34, 175–188. [Google Scholar]
- Hayat, K.; Zhang, X.; Chen, H.; Xia, S.; Jia, C.; Zhong, F. Liberation and separation of phenolic compounds from citrus mandarin peels by microwave heating and its effect on antioxidant activity. Sep. Purif. Technol. 2010, 73, 371–376. [Google Scholar] [CrossRef]
- Vineetha, N.; Vignesh, R.; Sridhar, D. Preparation, standardization of antibiotic discs and study of resistance pattern for first-line antibiotics in isolates from clinical samples. Int. J. Appl. Res. 2015, 1, 624–631. [Google Scholar]
- CLSI. Reference Method for Broth Dilution Antifungal Susceptibility Testing of Yeasts; Clinical and Laboratory Standards Institute: Wayne, PA, USA, 2008; pp. 1–28. [Google Scholar]
- Andrews, J.M. Determination of minimum inhibitory concentrations. J. Antimicrob. Chemother. 2001, 48, 5–16. [Google Scholar] [CrossRef] [Green Version]
- de Castro, R.D.; Lima, E.O. Anti-candida activity and chemical composition of Cinnamomum zeylanicum blume essential oil. Braz. Arch. Biol. Technol. 2013, 56, 749–755. [Google Scholar] [CrossRef]
- He, J.; Yin, T.; Chen, Y.; Cai, L.; Tai, Z.; Li, Z.; Liu, C.; Wang, Y.; Ding, Y. Phenolic compounds and antioxidant activities of edible flowers of Pyrus pashia. J. Funct. Foods 2015, 17, 371–379. [Google Scholar] [CrossRef]
| Sample | Process Time | Total Polyphenol Content (mg GAE/g dw) | Total Flavonoid Content (mg CE/g dw) | DPPH (IC50 mg/g) | Ferric Reducing Power (Absorbance 760 nm) |
|---|---|---|---|---|---|
| Basil | 5 min | 69.24 ± 1.03 c | 39.66 ± 0.08 d | 6.08 ± 0.15 b | 0.815 ± 0.012 c |
| 10 min | 66.22 ± 3.89 c | 39.00 ± 0.63 d,e | 6.39 ± 0.15 a | 0.789 ± 0.102 c,d | |
| 15 min | 54.64 ± 6.13 d | 36.79 ± 0.26 e | 6.62 ± 0.27 a | 0.712 ± 0.009 d | |
| Rosemary | 5 min | 122.84 ± 5.79 b | 78.36 ± 1.55 c | 0.79 ± 0.01 c | 1.426 ± 0.013 b |
| 10 min | 119.24 ± 2.47 b | 86.85 ± 2.80 b | 0.82 ± 0.03 c | 1.503 ± 0.040 a,b | |
| 15 min | 140.43 ± 4.44 a | 109.73 ± 0.33 a | 0.66 ± 0.01 d | 1.526 ± 0.037 a |
| Plant Extract | Rosemary Extract | ||||||||
|---|---|---|---|---|---|---|---|---|---|
| Microorganisms | Ethanolic Extract Rosemary | Methanolic Extract Rosemary | |||||||
| Zone of Inhibition (mm) | MIC (mg/mL) | MBC (mg/mL) | Growth on MH Agar | Zone of Inhibition (mm) | MIC (mg/mL) | MBC (mg/mL) | Growth on MH Agar | ||
| L. monocytogenes ATCC 19114 | 20 | 5 | 5 | NG/Bactericide | 15 | 5 | 5 | NG/Bactericide | |
| B. subtilis ATCC 6633 | 14 | 10 | 10 | +++/Bacteriostatic | 15 | 5 | 5 | NG/Bactericide | |
| S. typhimurium ATCC 14028 | - | - | - | - | - | - | - | - | |
| E. coli ATCC 10798 | - | - | - | - | - | - | - | - | |
| Sample | Process Time | Resorcinol | Chlorogenic Acid | Caffeic Acid | Vanillin | Acetyl Salicylic Acid | 3,5-DNSA | Salicylic Acid | Quercetin | Total |
|---|---|---|---|---|---|---|---|---|---|---|
| Basil | 5 min | ND | 20.38 ± 0.15 | 2.03 ± 0.23 | 1.64 ± 0.04 | 63.58 ± 0.83 | 24.87 ± 1.48 | 5.49 ± 0.09 | ND | 117.99 ± 2.82 |
| 10 min | ND | 19.23 ± 0.56 | 4.36 ± 0.67 | 16.52 ± 0.23 | 48.18 ± 0.67 | 19.32 ± 0.67 | 3.53 ± 0.68 | ND | 111.14 ± 2.81 | |
| 15 min | ND | 20.67 ± 0.69 | 2.72 ± 0.51 | 15.20 ± 0.35 | 122.61 ± 0.58 | 0.42 ± 0.35 | 1.44 ± 0.92 | ND | 163.06 ± 3.40 | |
| Rosemary | 5 min | 4.84 ± 0.26 | 25.56 ± 2.07 | 14.41 ± 1.38 | 2.28 ± 0.66 | 165.35 ± 1.21 | 42.99 ± 1.80 | 324.70 ± 2.50 | 165.99 ± 2.15 | 746.12 ± 12.03 |
| 10 min | 5.77 ± 0.28 | 5.76 ± 0.05 | 51.50 ± 1.32 | 3.78 ± 1.41 | 135.79 ± 3.62 | 87.17 ± 1.17 | 102.16 ± 1.11 | 137.10 ± 1.40 | 529.03 ± 10.36 | |
| 15 min | 5.28 ± 0.08 | 70.61 ± 0.37 | 14.63 ± 0.44 | 2.35 ± 0.37 | 161.81 ± 1.17 | 143.15 ± 0.78 | 166.91 ± 3.68 | 243.64 ± 0.61 | 808.38 ± 7.50 |
Publisher’s Note: MDPI stays neutral with regard to jurisdictional claims in published maps and institutional affiliations. |
© 2021 by the authors. Licensee MDPI, Basel, Switzerland. This article is an open access article distributed under the terms and conditions of the Creative Commons Attribution (CC BY) license (https://creativecommons.org/licenses/by/4.0/).
Share and Cite
Salamatullah, A.M.; Hayat, K.; Arzoo, S.; Alzahrani, A.; Ahmed, M.A.; Yehia, H.M.; Alsulami, T.; Al-Badr, N.; Al-Zaied, B.A.M.; Althbiti, M.M. Boiling Technique-Based Food Processing Effects on the Bioactive and Antimicrobial Properties of Basil and Rosemary. Molecules 2021, 26, 7373. https://doi.org/10.3390/molecules26237373
Salamatullah AM, Hayat K, Arzoo S, Alzahrani A, Ahmed MA, Yehia HM, Alsulami T, Al-Badr N, Al-Zaied BAM, Althbiti MM. Boiling Technique-Based Food Processing Effects on the Bioactive and Antimicrobial Properties of Basil and Rosemary. Molecules. 2021; 26(23):7373. https://doi.org/10.3390/molecules26237373
Chicago/Turabian StyleSalamatullah, Ahmad Mohammad, Khizar Hayat, Shaista Arzoo, Abdulhakeem Alzahrani, Mohammed Asif Ahmed, Hany M. Yehia, Tawfiq Alsulami, Nawal Al-Badr, Bandar Ali M Al-Zaied, and Mohammed Musaad Althbiti. 2021. "Boiling Technique-Based Food Processing Effects on the Bioactive and Antimicrobial Properties of Basil and Rosemary" Molecules 26, no. 23: 7373. https://doi.org/10.3390/molecules26237373
APA StyleSalamatullah, A. M., Hayat, K., Arzoo, S., Alzahrani, A., Ahmed, M. A., Yehia, H. M., Alsulami, T., Al-Badr, N., Al-Zaied, B. A. M., & Althbiti, M. M. (2021). Boiling Technique-Based Food Processing Effects on the Bioactive and Antimicrobial Properties of Basil and Rosemary. Molecules, 26(23), 7373. https://doi.org/10.3390/molecules26237373

